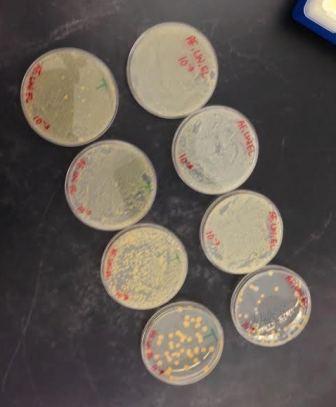

User:Ashlee Forbes/Notebook/Biology 210 at AU
7/22/2014 Bacterial 16S Identification
Bacteria from Transect 5 were run through a PCR analysis in order to amplify their DNA. After running an electrophoresis gel, the bacteria were sent off to a lab for genetic sequencing. Unfortunately, only one PCR reaction amplified enough to get a proper sequence; that reaction was not ours. The following nucleotide sequence came from a nearby transect, the tall bushes:
AAGATTAATACCCCATAATATTTTAAGTGGCATCACTTGAAATNGAAAACTCCGGTGGATAAAGATGGGCACGCTCAAGATTAGATAGTTGGTAGGGTAACGGCCTACCAAGTCTACGATCTTTAGGGGGCCTGANAGGGTGATCCCCCACACTGGTACTGAGACACGGACCANACTCCTACGGTAGGATCAGTGAGGAATATT
Running this sequence through NCBI's database gave us a match for the DNA of bacteria Chryseobacterium with a 95% match rate.
Chryseobacterium are most commonly found in soil, plants, and water sources, a fact consistent with the location from which the bacteria sample was pulled. Chryseobacterium is likely to have also been in Transect 5, and will serve as the sample from our transect owing to the fact that this ecosystem has not been analyzed before and there is no existing information to analyze.
7/17/2014 Embryology & Zebrafish Development
The purpose of today's activity was to observe egg and fetal development in a variety of animal species. We focused on starfish, frogs, and chickens.
We looked at slides detailing various stages of development in these three animals, noting yolk size and placement, blastulation and gastrulation patterns, as well as larval stages, if any. For the chicken, we cracked open fertilized eggs and observed these under the dissecting scope. All other forms were observed on prepared slides using compound microscopes. Observations were logged in two tables along with what is known about human eggs, for contrast.
Findings were surprising in that human eggs are similar in many ways to starfish eggs, rather than the two vertebrate species observed. Every animal had its own unique development pattern, however, leading to the conclusion that animal development is varied and specialized.
7/14/2014 Invertebrates & Invertebrates
The purpose of today's experiment was to observe vertebrate and invertebrate species occurring in Transect 5. To that end, examples of invertebrate species were observed in the lab to help identify the different types and species of invertebrates found in samples of leaf litter from the transect. Because of the diversity deliberately built into this particular ecosystem, the prediction is that we will observe a variety of invertebrate species, though no worms are expected due to the shallow depth at which litter were collected. For the purposes of this experiment, the hypothesis is: If leaf litter is collected from Transect 5, a variety of invertebrate species will be observed, most of them being arthropods.
Materials & Methods
Last week, the experimenters traveled to Transect 5 and collected leaf litter samples from various locations throughout the transect. The samples included fallen, decaying leaves, some topsoil, woodchips, and a small amount of live plant material. These were then placed into a Berlese Funnel setup to collect any invertebrates.
For the Berlese Funnel, a plastic funnel was lined with mesh and fitted to a plastic 50 ml tube filled with 25 ml of a 50:50 ethanol/water solution. The apparatus was sealed together with tape to ensure that the ethanol would not evaporate. Leaf litter was then placed into the funnel opening and the whole apparatus suspended in a ring stand. The Berlese Funnel was then put under an incandescent light bulb with the outside tented in aluminum foil to ensure concentrated rays directed toward the leaf litter. The lighted setup was left on the lab bench for 5 days.
After 5 days, the Berlese Funnel setup was broken down. The tube filled with ethanol solution was preserved, and the top layer poured into one petri dish, while the bottom layer was poured into a second petri dish, both for observation using a dissection scope.
Before observing these samples, we looked at cross-sections and whole samples of a variety of invertebrates. These included the acoelomate flatworms Planaria (cross-section and wet mount), the coelomate Annelida (cross-section and dead specimens), the pseudocoelomate nematode (cross-section only), and leeches (specimens preserved in ethanol).
Sample petri dishes were then observed, with any invertebrate forms recorded.
A second visit was made to the transect at the conclusion of this procedure, in order to observe vertebrate species. These were recorded, classified and analyzed according to their place in the food chain of the transect.
Data & Observations
Because the Planaria were live specimens, we were able to observe their movement, comparing it to the known movements of Annelida and nematodes. Because these three species belong to the acoelomate, coelomate and pseudocolomate families, respectively, their movements aid in digestion and feeding. Planaria move smoothly through narrow crevices, allowing them to force food through the opening that serves as a mouth, rapidly passing it through their excretory end. This is achieved through the use of cilia. Annelida, being coelomates, have a body cavity and are segmented. These are represented well by earthworms, who move with an expanding and contracting motion, allowing them to push food through their bodies as they move, more efficiently excreting waste. Pseudocolomates like nematodes are somewhat unknown in their anatomy and mechanisms, but move like whips, undulating. Their movement is more advanced than acoeolomates, but less so than coelomates because they are intermediate in digestive, nervous, and circulatory system development.
Among the invertebrates observed in the leaf litter, arthropodic forms were the most common. A total of five types were identified and characterized (Table 1). The five found were millipedes, pill bugs, termites, ground spiders and Springtails, with the millipede being the largest. Two termites were found, making them the most numerous found as every other type was only singular in count. These five organisms ranged in length from 1.5 mm to 6 mm. A chart detailing common soil invertebrates (Figure 1) was used to aid in the identification of these specimens.
After observing vertebrate activity in the transect, not much variety was found. To that end, neighboring areas of the transect were observed to find vertebrates that might occasion the space. The types observed were birds (sparrows and robins) and rodents (squirrels, mice and chipmunks). Their classifications follow in Table 2.
Biotic components benefiting these animals would be seeds and water as food sources for both rodents and birds, and insects as food sources for the birds. Both animal groups also doubtlessly benefit from any food litter left by passing humans. The trees are also a biotic benefit as both birds and and squirrels are arboreal creatures, making their nests in the branches from leaf litter and organic debris. Abiotic elements of the transect that benefit both animal groups are the moderate temperature, heavily shaded by trees, abundant rainfall which gives both groups a water source, and sunlight that grows the plants they all depend upon for environmental cover. A food web describing their roles alongside the other organisms present in the transect is below (Figure 2).
Conclusions & Future Directions
After observing vertebrates, invertebrates, bacteria and plants in Transect 5, it can be concluded that Transect 5 comprises a small ecosystem. A community is present as more than two distinct species are present, and they interact in a meaningful way. Carrying capacity is demonstrated in how sparsely populated the area is with vertebrates, they being unable to thrive to an abundant level on such a small amount of resources in such a small area. Because of the trophic levels, or position in the food chain, for each of the observed species, there are only so many biological forms that can be sustained. There appears to be no such carrying capacity for bacteria.
7/10/2014 Plantae & Fungi
The purpose of the experiment described herein was to practice identification of plants and fungi. In particular, focus was placed on the plants in the different transects, specifically Transect 5. Because of the prevalence of trees and shrubs in the transect, the prediction is that most of the selected plants will be dicots rather than monocots. The hypothesis will be: If five plants are chosen at random from Transect 5, then a majority will be monocots.
Materials & Methods
Five plants were chosen from the transect at various locations. A selection of leaves from trees, grasses, moss and ferns were chosen and specimens removed from plants in a minimally invasive manner. Several of the plants were known and readily identified, but the remainder were researched outside of the lab.
Sample #1 is a leaf taken from a shrub with purple flowers, located midway through the transect, and largely shaded by trees. Sample #2 is taken from a low-lying, creeping plant occurring along the path in the transect. The sample is bright green with small, needle-like leaves. Sample #3 is a leaf taken from a tree located near the periphery of the transect. The tree was woody and of middling height with mottled, smooth bark. Sample #4 is a frond taken from a plant identified as a fern. The frond was small and light green in color Sample #5 is a blade of a type of grass, taken from a grass covering most of the ground in various places throughout the transect.
Plants were also examined and observed for evidence of vascularization patterns. The transect was patrolled for seeds, dead leaves, and any evidence of reproductive methods. Back in the lab, the samples were examined using dissecting and compound microscopes to determine vascularization, structure, and to identify their grouping. Special attention was paid to whether any samples might be fungi.
Data & Observations
Results of testing are featured in Table 1, below:
File:Ashlee Forbes - Plant Table.doc
Samples 1, 3 and 5 were found to be angiosperms, while 2 was a bryophyte, 4 was a Pteridophyta fern. Only the bryophyte moss is non-vascular, instead carrying water from soil to leaves. All the angiosperms and the fern use phloem and xylem to transport water and nutrients through their stems.
Although the fern sample we collected did not have spores on its backside, it nonetheless reproduces using spores. Observation of the other plants' leaf structures and flower structure revealed them to be monocots (in the case of the grass with parallel leaf striations) and dicots (in all other cases, particularly with the 5-petal flowers).
No fungi were observed.
Conclusions & Future Directions
Transect 5 had changed before its second examination. New plantings had been put in and the path altered, probably to accommodate the summer season. Most of our plants were in fine, healthy condition, although it was noticed that the fern was close to death due to its very light green color and diminished appearance.
Observing Microbacteria 7/8/2014
The purpose of the experiment described herein was to cultivate and observe prokaryotes present in Transect 5, a certified wildlife habitat in front of Hughs Hall on the campus of American University. More specifically, the organisms being observed were bacteria, as archaea (the other branch of the prokaryote group) were unlikely to be present on the AU campus, although it can be predicted that there will be a large amount of bacteria. The effects of tetracycline on these bacteria are also being tested. For the purposes of this experiment, the hypothesis will be: If bacteria are cultivated from a hay infusion of biotic material from Transect 5, half being treated with tetracycline, then the untreated bacteria will flourish more than the bacteria in the presence of tetracycline.
Materials and Methods The Hay infusion was agitated to mix up the organisms it contained. Then 100 μL were drawn from the middle of the jar, halfway to the bottom. These 100 μL were added to a plastic tube containing 10 ml of sterile broth. The tube was labeled 10-2 (a 1:100 dilution). 100 μL from that tube were then added to another plastic tube containing 100 ml of sterile broth for a 1:10,000 dilution(10-4). This process was repeated to form a 1:1,000,000 dilution and a 1:100,000,000 dilution, labeled 10-6 and 10-8, respectively. 100 μL of each of these dilutions were added to petri dishes containing nutrient agar. 100 μL of the 10-2 solution were spread on the surface of nutrient agar in petri dishes labeled 10-3, one gel containing tetracycline, the other left plain. This was repeated for each of the other tubes, with 10-4 going into dishes labeled 10-5 and so on. A glass spreader was used for procedure, and sterilized in a flame between applications. The agar dishes were covered and left to incubate in sunlight for five days.
After five days, bacterial growth on the agar plates was observed and recorded using dissection and compound microscopes. To aid in viewing the bacteria, a Gram stain procedure was performed. A smear from four of the plates (two plain, two with tetracycline) was put onto a glass slide plate and mixed with a drop of water. The smear was heat fixed by passing the slide through a flame with the bacterial smear facing upward. Smears were then covered with crystal violet for one minute, then rinsed with water. The smears were then treated with Gram's iodine for one minute, then rinsed with water. The smears were then decolorized with a 95% alcohol solution for 10 seconds, then stained with safranin stain for 30 seconds. The slides were rinsed with water and blotted for excess water before being left to air dry for 15 minutes. Slides were observed using compound microscopes set for 40x and 100x.
Data and Observations No archaea were observed in the bacterial growth plates. Upon opening the petri dishes, there was a noticeable fecal smell from the bacterial growth. The bacterial growth was about twice as effective on the plain nutrient agar plates vs. the plates treated with tetracycline (Image 1, Table 1).
On the highest dilutions, about 35 bacterial colonies were observed on tetracycline plates, while 61 were observed on the untreated plates. Each plate had a growth of yellow bacterial colonies, with the higher dilutions having more distinct colony formation. The untreated 10-9 plate also had some white colonies in evidence (Image 1).
Four samples were selected for microscopic observation: the tetracycline treated 10-3 and 10-9 (T3 and T9) and the untreated 10-5 and 0-9 (U5 and U9). Tetracycline treated plates showed a growth of cocci bacteria, and were slightly larger, where the untreated plates showed a growth of bacilli, being slightly smaller. Full results are featured in Table 2 below.
Conclusions The data from the experiment supports the hypothesis. The bacteria on untreated plates did twice as well as the tetracycline treated plates. This is because tetracycline inhibits bacterial growth by inhibiting the synthesis of protein. Many forms of bacteria are susceptible to tetracycline because of this, but are only inhibited rather than killed. Because of its widespread use as an antibiotic, this has also resulted in several strains of resistant bacteria.
As expected, no archaea were observed. This is due to the mild environment, whereas archaea are usually found in climates that are extremely hot, saline and methane rich. The AU campus is none of those things.
In another run of this experiment, agar plates might be left longer to encourage more bacterial growth. The experimenters would also not rinse as heavily, as this washed away most of the bacteria on the plates. This would undoubtedly result in more bacteria as well as a stronger smell due to the proliferation of more bacteria.
Observing Protists in Transect 5 7/3/2014
The purpose of the experiment detailed in this notebook was to observe protists in a hay culture. The hay culture was made from a soil and vegetation sample taken from Transect 5, a certified wildlife habitat on the campus of American University in Washington, DC. Because of the site’s unique status, the expectation here will be to see a large amount of protest life in the sample. A large amount of biotic life should be observed if the site is planted specifically to encourage wildlife. The hypothesis for this experiment will be: If samples of a hay culture from Transect 5 are observed, then a large number of protists will be observed.
Materials and Methods For this experiment, a 50 ml conical tube was used to take a soil and vegetation sample. Sample was collected from various areas around the transect, and comprised of ground mosses, grass, and topsoil. The sample was then mixed to combine components thoroughly.
In the lab, a Hay Infusion Culture was created using the soil sample. Eleven grams of the soil and vegetation sample were weighed and put into a large glass jar along with 500 ml of Deer Park water. To this, 0.1 grams of milk powder were added to the soil solution. The jar was then sealed, shaken to mix, then left uncovered for two days. After two days, a pipette dropper was used to pull samples from the culture. Samples were taken from the very top layer and from the bottom of the infusion, just about the solid layer. Specimens were observed at both 10x and 40x magnification using compound microscopes.
Data and Observations After two days, the hay culture was showing clear signs of decomposition. The jar had a pungent rotting smell and pieces of vegetation were blackened and floating on the surface. A light scummy film had begun to coat the water surface as well (Figure 1).
Figure 1: Hay Infusion after 2 days
Under microscopic observation, however, there was a noted absence of life. The sample drawn from the top layer of the infusion did not contain any protists, although some plant cells were observed, though none were algae-based. The sample taken from the bottom layer returned slightly better results, with a few motile paramecium in evidence (Figure 2). These measured approximately 75 µm in length. Paramecium were identified with the aid of a dichotomous key.
Conclusions and Future Directions The hypothesis was not supported by the evidence collected in this experiment. There was a noted dearth of living organisms within the hay culture, in spite of decompositional signs. It can be concluded that the infusion would have had more protist life present had it incubated for a longer period of time. If the infusion were left for two months, for example, rather than two days, protist life would likely flourish as decomposition would be more advanced and the protists would have more of a food source and more time to reproduce.
Paramecium are well suited for this environment, having all the components of life (energy consumption and use, a distinct cell wall, storage of information) and their mode of replication is unique in that it can be both sexual and asexual. In an environment like a two-month-old hay culture, organisms like paramecium would likely be numerous, while the soil and vegetation would be greatly degraded.
To improve the experiment were I to replicate it, I would leave the hay infusion to incubate for longer. I would also take a sample from the solid layer itself since the majority of life appears to be closer to the biological material there (close to the food source) rather than on the top layer.
Surveying Life at American University 7/1/2014
The purpose of the experiment detailed herein was to observe and survey the biological life on the campus of American University in Washington, DC. This entry specifically addresses a 20' x 20' transect: the Certified Wildlife Area in front of Hughs Hall.
Surveying Life at American University 7/1/2014
The purpose of the experiment detailed herein was to observe and survey the biological life on the campus of American University in Washington, DC. This entry specifically addresses a 20' x 20' transect: the Certified Wildlife Area in front of Hughs Hall. Because the site is certified as a wildlife area, the expectation here is to have a wide variety of biotic lifeforms. The hypothesis for the purposes of this experiment will be as follows: If the transect is observed and sampled, then a wide variety of biotic life will be observed.
Materials and Methods The nature of this experiment being observation-based, the only materials needed and used were the eyes of the experimenters, a camera, and paper and pencil to record observations. The transect was observed, and topography as well as biotic and abiotic forms were recorded.
Data and Observations The observed transect was a 20’ x 20’ certified wildlife area in front of Hughs Hall on the campus of American University. A variety of plant forms were observed, among them trees, shrubs, ground moss, and flowering plants.
The site is bounded by two large oak trees, with two smaller, woody trees (possibly crepe myrtle) in the center. The majority of the ground cover is provided by day lilies (mondo grass) and ground moss. Hosta and an unidentified plant with feathery flowers (Figure 1) were observed as the low shrubs. Ground cover was about 80% of the vegetation observed.
Figure 1: Unidentified plant with flowers like feathers.
The site (Figure 2) has a gently sloping topography, providing very good drainage for the area, so the soil was dry at time of observation. No animal species were observed in the site, but insects in the form of ants were present throughout the site. The transect is well shaded, owing to the spread of the oak trees on the site. This means the area is largely cool and receives medium levels of dappled light. Abiotic components of the site included stone slabs, placed as walking stones, and a garden bench.
Figure 2: Aerial drawing of transect.
Conclusions and Future Directions The observations taken at the transect site supported the original hypothesis. A wide variety of biotic life was observed. Animal life was notably absent from the transect, but many plant forms were in evidence. A more in-depth look at this transect, including culturing bacteria taken from soil and vegetation would be a logical follow-up if more information is desired.